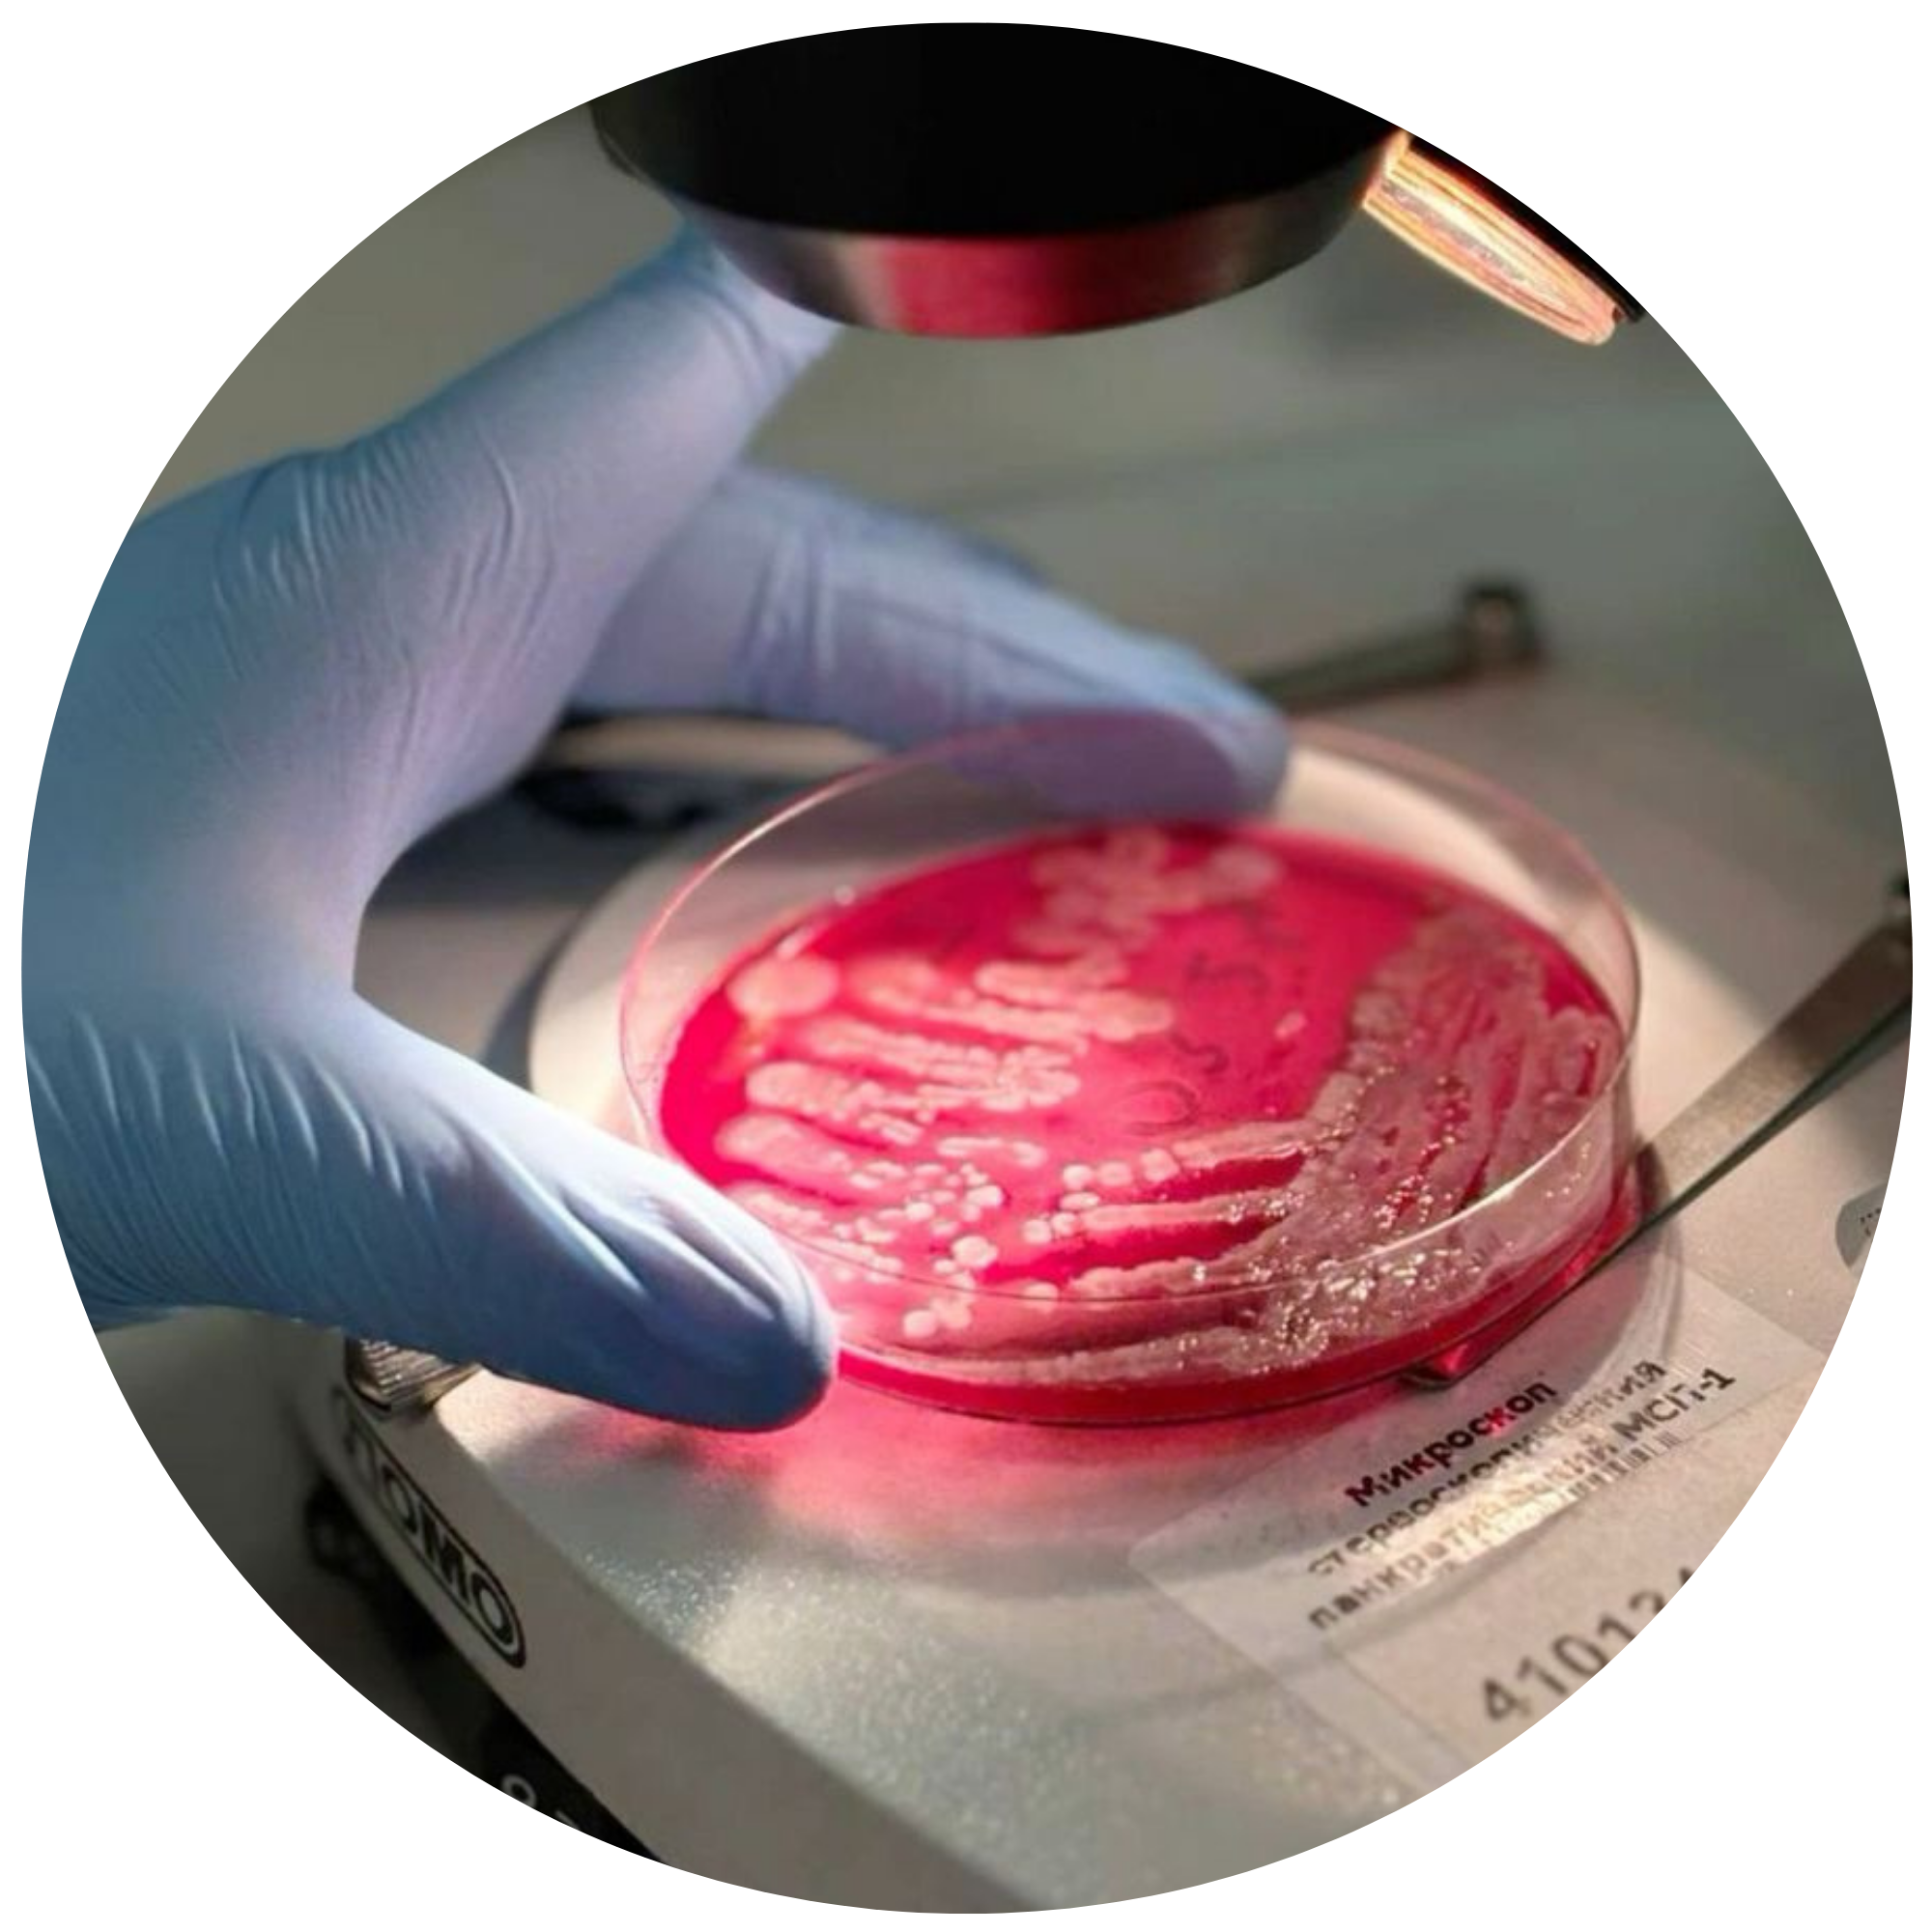
MICROBIOLOGY

ANIMAL HEALTH
We offer reliable diagnostic kits for animals. health, supporting veterinary labs in monitoring disease, and ensuring biosecurity. and improving livestock care.
FEED & FOOD SAFETY
We provide diagnostic kits and tools that support feed and food safety testing. Helping ensure product quality, regulatory compliance, and consumer protection across the supply chain.
PLANT HEALTH
We provide diagnostic kits and tools that support feed and food safety testing. Helping ensure product quality, regulatory compliance, and consumer protection across the supply chain.
CHEMISTRY
We provide a full suite of analytical chemistry instruments, including precision pH meters and specialized laboratory furniture designed to safely handle strong acids and bases. Our portfolio also features fume hoods and other essential lab solutions, ensuring accuracy, safety, and efficiency in every chemical workflow.
MICROBIOLOGY
We offer a comprehensive range of microbiology solutions, from trusted reference strains by Microbiologics and innovative automation tools by IUL, to reliable sterilization systems from Equitron. Complementing these are essential consumables such as petri dishes, inoculating loops, and other daily-use lab supplies—ensuring precision, efficiency, and confidence in every workflow.
MOLECULAR
Advanced molecular kits and equipment for RT-PCR workflows, including gel documentation systems and RT-PCR reagents. Ideal for pathogen detection. gene expression analysis, and laboratory diagnostics
OPTICAL IMAGING & ANALYSIS
We deliver cutting‑edge optical imaging and analysis solutions with Ocean Optics spectrometers and Motic microscopes, combining spectral precision with high‑quality visualization.
LABORATORY FURNITURE
We offer Kottermann laboratory furniture, renowned for its durability, safety, and modular design tailored to modern laboratories. Built from high‑quality steel, Kottermann systems include fume cupboards, workstations, and storage solutions that ensure ergonomic efficiency and maximum protection when handling hazardous chemicals, acids, and bases—providing a reliable foundation for safe and compliant laboratory environments.
RESEARCH & DEVELOPMENT
Our portfolio includes specialized access to Native Antigen, supporting the development and validation of both antigen and antibody assays. These high‑quality biological materials provide reliable foundations for diagnostic research, vaccine development, and immunological studies, ensuring accuracy, reproducibility, and confidence in advancing scientific innovation.
WATER & ENVIRONMENT
Kits and equipment for water and environmental testing. Ideal for monitoring microbial contamination, assessing water quality, and supporting regulatory compliance in public health and industrial settings.
INSTRUMENTS
instruments are tools and devices used to perform scientific experiments, measurements, and analyses. They help researchers and students accurately observe, test, and record data during laboratory activities. These instruments ensure precision, safety, and efficiency in conducting experiments and studying scientific processes.

About FIL-ANASERVE, INC.
FIL-ANASERVE, INC. is a 100% Filipino-owned company proudly serving the Philippine market since 2001. With over two decades of experience, we specialize in providing high-quality products and solutions for the analytical and industrial sectors.
Core Markets
Agriculture, Food Safety, Pharma, Molecular Biology, & Environmental Testing.
Our Solutions
From lab consumables and test kits to high-end analytical instrumentation.
At FIL-ANASERVE, we are committed to supporting scientific advancement by delivering reliable products and responsive service tailored to our clients’ evolving needs.
"We take pride in our excellent after-sales service and our team of dedicated Sales Representatives, ensuring personalized attention throughout your journey."
Featured Products
Events

PSBMB CONVENTION
PSBMB CONVENTION Fil Anaserve proudly participated in the annual convention of the Philippine Society for Biochemistry and Molecular Biology (PSBMB) held last December 3–5, 2025, as a Platinum Sponsor. The event gathered biochemists, molecular biologists, researchers, educators, and industry partners to share breakthroughs and innovations in the life sciences. As a Platinum Sponsor, Fil Anaserve showcased its comprehensive range of scientific and laboratory solutions, engaged with delegates, and supported the convention’s mission of advancing biochemical and molecular biology research in the Philippines. Our team provided product insights, demonstrations, and technical guidance to help empower research and academic laboratories nationwide. We are honored to have contributed to this significant scientific gathering and remain committed to supporting the country’s growing research community
.png)
SYSMEX WORKSHOP
Fil Anaserve successfully conducted a SYSMEX Workshop in Nueva Ecija on November 17, 2025, bringing together laboratory professionals for a focused, hands on learning experience. The session covered essential operational techniques, best practices and proper maintenance procedures for SYSMEX equipment. Participants engaged in live demonstrations, troubleshooting discussions, and practical exercises designed to enhance their confidence and efficiency in using SYSMEX flow cytometry. The workshop also provided an opportunity for attendees to consult directly with our technical team and exchange insights with fellow laboratory practitioners in the region. This initiative reflects our commitment to supporting laboratories with continuous training, updated technical knowledge, and reliable after sales service.

ILOCOS REGION COVERAGE
In March 2025, Fil Anaserve conducted a regional coverage activity across the Ilocos Region, visiting several universities to showcase our laboratory equipment and solutions. During these visits, end users had the opportunity to see the units in person, explore their features, and interact directly with our team. The onsite demonstrations allowed faculty members, and researchers to better understand the capabilities of the equipment and how these can support their academic and laboratory needs. This initiative reflects our commitment to bringing accessible, hands on product experience to institutions across the region.
Trusted by Top Global Brands